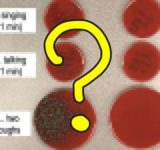

-
『FFCC リマスター』サントラ発売決定‥完全新曲やフルの主題歌を含む50曲以上を収録
投稿日 2020年6月29日 19:40:00 (アニメ・ゲーム)
-
名古屋前田「局面で負けなければ」再開へ意気込み
投稿日 2020年6月29日 19:37:26 (スポーツ)
-
7・1にJカンファレンス開催、再開見どころ紹介
投稿日 2020年6月29日 19:33:26 (スポーツ)
-
アメリカの専門医「マスクの有無で、感染力の違いがひと目でわかる実験を行った」海外の反応
投稿日 2020年6月29日 19:31:53 (ニュース)
-
ボスの『カフェベース』を最高に美味く飲む方法! そのままアイストレーに流し込んで「コーヒー氷」にするべし
投稿日 2020年6月29日 19:30:59 (ニュース)
-
『ガルパン』水島努監督「クールジャパン(笑)こっちくんな」「クールジャパンって自分から言っちゃうのが、非常に薄気味悪い」
投稿日 2020年6月29日 19:30:58 (アニメ・ゲーム)
-
【悲報】銀行口座ないと働ける場所ない
投稿日 2020年6月29日 19:30:15 (総合)
-
美人すぎるマジシャン 御寺ゆきランジェリ画像 2020
投稿日 2020年6月29日 19:20:00 (その他)
-
PS5はPS4の初期価格と同じ39,980円(税抜)で発売されたら嬉しい
投稿日 2020年6月29日 19:20:00 (アニメ・ゲーム)
-
韓国「隣国に害を与えることに慣れた日本の一貫して反省しない態度にはもう驚きもしない」「恥知らず」
投稿日 2020年6月29日 19:10:24 (ニュース)
-
職場でカップ麺を食べるのは“スメハラ”!?ネット上で議論に – ABEMA TIMES
投稿日 2020年6月29日 19:06:00 (ニュース)
-
【乃木坂46】“白石麻衣のそっくりさん”インスタグラマー・清水愛美の全貌が明らかに!!!!!!
投稿日 2020年6月29日 19:05:15 (芸能)
-
「777TOWN.net」に対戦アクションゲーム「バトル オブ ボックス」β版が登場
投稿日 2020年6月29日 19:05:06 (アニメ・ゲーム)
-
【乃木坂46】齋藤飛鳥『秋元さんみたいに後輩を狙い撃ちして優しくするっていうのは私はやってない・・・』
投稿日 2020年6月29日 19:04:02 (芸能)
-
「Fate/Grand Order」でサーヴァント6騎の「幕間の物語」が新たに登場
投稿日 2020年6月29日 19:02:09 (アニメ・ゲーム)
-
外国人「アニメの声も人種どおりにキャストしろ!白人なのに非白人キャラの声を担当するな!」
投稿日 2020年6月29日 19:00:29 (アニメ・ゲーム)
-
「韓国政府からあなたを入国禁止に、と電話が」挺対協と対立した日本人が受けた仕打ち 「挺対協」“嫌韓”を作った組織の30年 #5 – 赤石 晋一郎 – 文春オンライン
投稿日 2020年6月29日 19:00:00 (ニュース)
-
身内に不幸があり、2日間部活を休む事に…その際にラインで部のみんなに伝えると、先輩が『ご迷惑をおかけします、ってどういうこと?』と…
投稿日 2020年6月29日 19:00:00 (生活)
-
【G7参加“反対”報道】韓国政府高官、激おこ「隣国に害を与えることに慣れた日本の一貫して反省しない態度にはもう驚きもしない」「恥知らず」
投稿日 2020年6月29日 18:59:37 (ニュース)
-
「妖怪ウォッチ ワールド」2周年記念イベントが開催。記念コインキャンペーン実施
投稿日 2020年6月29日 18:59:31 (アニメ・ゲーム)
-
「ブラスターマスター ゼロ」「ブラスターマスター ゼロ 2」のPS4版が本日リリース。DLC「カンナを育てまストランガ!」の配信も
投稿日 2020年6月29日 18:58:58 (アニメ・ゲーム)
-
「ダービーインパクト」,1000万DL突破記念のさまざまなキャンペーンが本日開始
投稿日 2020年6月29日 18:52:41 (アニメ・ゲーム)
-
6月29日(月)ムネオ日記 – 鈴木宗男
投稿日 2020年6月29日 18:50:00 (ニュース)
-
自分のハレンチな姿を撮られて興奮しちゃうヤリマン素人女子達の画像を集めてみたwww
投稿日 2020年6月29日 18:40:00 (その他)
-
ウイルス研究者「ウイルス学を完全否定された感じ」最近流行りのAIによる飛沫観察はほとんど意味を成していない
投稿日 2020年6月29日 18:35:43 (総合)
-
東京都の感染者数、1週間平均が50人越え!再休業の基準を越えてしまう・・・これもしかして・・・
投稿日 2020年6月29日 18:30:37 (アニメ・ゲーム)
-
マクドナルド「世界のビーフバーガー」を食べ比べてみた結果 → 日本代表がセルジオ越後もブチキレるレベル
投稿日 2020年6月29日 18:30:01 (ニュース)
-
関東大学サッカー「試合数多く」早期リーグ開幕意図
投稿日 2020年6月29日 18:28:00 (スポーツ)
-
NAZO×NAZO劇団「異世界へのサーバー接続中にエラーが発生しました。」 公演感想まとめ
投稿日 2020年6月29日 18:25:27 (総合)
-
あおり運転、あすから厳罰化へ 懲役刑・一発免許取り消し
投稿日 2020年6月29日 18:23:10 (ニュース)